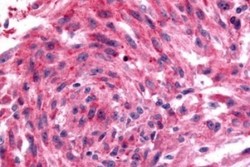

Antibody data
- Antibody Data
- Antigen structure
- References [0]
- Comments [0]
- Validations
- Immunohistochemistry [6]
Submit
Validation data
Reference
Comment
Report error
- Product number
- NLS4048 - Provider product page

- Provider
- Novus Biologicals
- Proper citation
- Novus Cat#NLS4048, RRID:AB_10003297
- Product name
- Rabbit Polyclonal Adrenomedullin R/ADMR/GPR182 Antibody
- Antibody type
- Polyclonal
- Description
- Immunogen affinity purified. Human GPR182/ ADMR. BLAST analysis of the peptide immunogen showed no homology with other human proteins.
- Reactivity
- Human, Simian
- Host
- Rabbit
- Isotype
- IgG
- Vial size
- 0.05 ml
- Concentration
- 1 mg/ml
- Storage
- Store at 4C short term. Aliquot and store at -20C long term. Avoid freeze-thaw cycles.
No comments: Submit comment
Supportive validation
- Submitted by
- Novus Biologicals (provider)
- Main image

- Experimental details
- Immunohistochemistry-Paraffin: Adrenomedullin R/ADMR/GPR182 Antibody [NLS4048] - Staining of untransfected HEK293 human embryonic kidney cells.
- Submitted by
- Novus Biologicals (provider)
- Main image

- Experimental details
- Immunohistochemistry-Paraffin: Adrenomedullin R/ADMR/GPR182 Antibody [NLS4048] - Analysis of transfected cells expressing GPR182 using NLS4048 at 17 ug/ ml.
- Submitted by
- Novus Biologicals (provider)
- Main image

- Experimental details
- Immunohistochemistry-Paraffin: Adrenomedullin R/ADMR/GPR182 Antibody [NLS4048] - Anti-GPR182 / ADMR antibody IHC of human Lung, Small Cell Carcinoma. Immunohistochemistry of formalin-fixed, paraffin-embedded tissue after heat-induced antigen retrieval.
- Submitted by
- Novus Biologicals (provider)
- Main image

- Experimental details
- Immunohistochemistry-Paraffin: Adrenomedullin R/ADMR/GPR182 Antibody [NLS4048] - Anti-GPR182 / ADMR antibody IHC of human adrenal, zona fasciculata. Immunohistochemistry of formalin-fixed, paraffin-embedded tissue after heat-induced antigen retrieval.
- Submitted by
- Novus Biologicals (provider)
- Main image

- Experimental details
- Immunohistochemistry-Paraffin: Adrenomedullin R/ADMR/GPR182 Antibody [NLS4048] - Anti-GPR182 / ADMR antibody IHC of human Brain, Glioblastoma. Immunohistochemistry of formalin-fixed, paraffin-embedded tissue after heat-induced antigen retrieval.
- Submitted by
- Novus Biologicals (provider)
- Main image
- Experimental details
- Immunohistochemistry-Paraffin: Adrenomedullin R/ADMR/GPR182 Antibody [NLS4048] - Anti-GPR182 / ADMR antibody IHC of human Skin, Melanoma. Immunohistochemistry of formalin-fixed, paraffin-embedded tissue after heat-induced antigen retrieval.